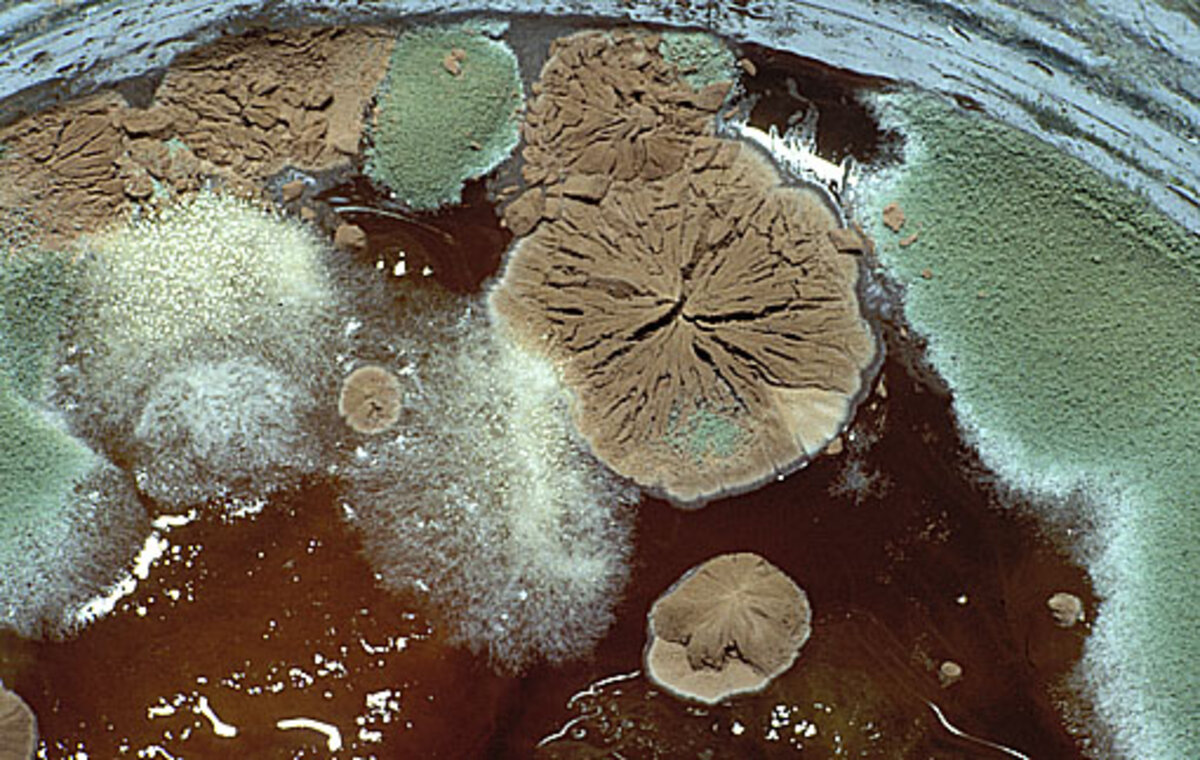
Illustration 1

Les cookies et technologies similaires que nous utilisons sur Mediapart sont de différentes natures et nous permettent de poursuivre différentes finalités.
Certains sont nécessaires au fonctionnement du site et de l’application mobile (vous ne pouvez pas les refuser). D’autres sont optionnels mais contribuent à faciliter votre expérience de lecteur ou de lectrice et d’une certaine façon à soutenir Mediapart. Vous pouvez les refuser ou les accepter ci-dessous, selon leurs finalités.
Acceptez-vous que Mediapart utilise des cookies ou technologies similaires pour les finalités suivantes ?
Vous pouvez faire votre choix, pour chaque catégorie, en activant ou désactivant le bouton interrupteur.
Nécessaires au fonctionnement
du site ou de l’application
Connexion des abonné·es, mesure d’audience anonymisée, envoi des notifications push, suivi des pannes, mise en avant de nos services : ces outils sont nécessaires au suivi de l’activité de nos services et à leur bon fonctionnement.
Voici les différents cookies et technologies similaires compris dans cette catégorie :
- Cookies d’authentification : connexion des abonné·es.
- AT Internet : mesure d’audience anonymisée
- Affichage de contenus éditoriaux multimédias : vidéos (YouTube, Dailymotion, Vimeo, INA), réseaux sociaux (Facebook, Instagram, Pinterest, Twitter), documents (Scribd, Document Cloud, Slideshare), sons (SoundCloud, Spotify, Deezer), cartes (Google Maps, Mapbox, CartoDB, uMap), infographies (Highcharts, GitHub, Datawrapper, Flourish, Infogram, ThingLink, jQuery, Google Fonts, Bootstrap), live blogs (24liveblog, CoverItLive), aide à l’intégration de média dans les publications Journal et Club (Embedly).
- Typeform : questionnaires facultatifs pour recueillir les avis des lecteurs sur nos produits numériques.
- Datadog (uniquement sur le site web) : indicateurs techniques et équilibrage de charge.
- Selligent (uniquement sur le site web) : communication avec l’abonné·e, mise en avant des services, offres et avantages.
- Batch (uniquement sur l’application) : envoi de notifications push et de messages in-app.
- Firebase Cloud Messaging (uniquement sur l’application) : nécessaire au fonctionnement des notifications push sur Android.
- Microsoft App Center (uniquement sur l’application) : système de mise à jour et de suivi des pannes de l’application.
Ces outils nous permettent de recueillir des statistiques de fréquentation du site et de l’application mobile pour comprendre les usages, détecter d’éventuels problèmes et optimiser l’ergonomie de nos produits.
Voici les outils tiers compris dans cette catégorie :
- AT Internet : mesure d’audience reliée à l’identifiant d’abonné·e.
- CrazyEggs (uniquement sur le site web) : analyse de parcours client.
- Nonli (uniquement sur le site web) : permet à notre équipe des réseaux sociaux de publier les contenus Mediapart sur les réseaux sociaux.
- Qiota (uniquement sur le site web) : gestion du système de datawall.
Il n’y a pas de publicité sur Mediapart. Mais nous faisons la promotion de nos contenus et services sur d’autres sites et réseaux sociaux. Pour cela, nous utilisons les technologies mises à disposition par certains acteurs publicitaires.
Voici les outils tiers compris dans cette catégorie :
- Facebook (uniquement sur le site web) : ciblage d’audience sur les réseaux sociaux pour faire la promotion de Mediapart.
Gestion de l’accès aux contenus
Nous utilisons le service Qiota d’Opper Marketing Suite pour configurer l’activation d’un datawall sur certains de nos contenus (uniquement sur le site web). Ce dispositif destiné aux utilisateur·ices non abonné·es requiert la saisie d’une adresse email pour accéder aux contenus concernés. En fournissant cette information, l’utilisateur consent à sa collecte, son stockage et son utilisation à des fins statistiques. Conformément à la réglementation en vigueur, les utilisateurs disposent d’un droit d’accès, de rectification et de suppression de leurs données, qu’ils peuvent exercer en contactant dpo@opper.io.